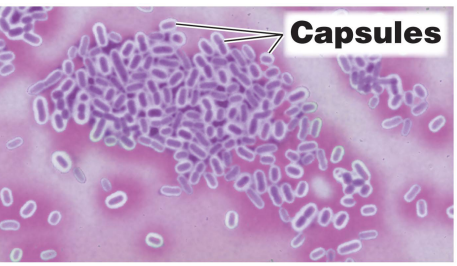
<p>How do capsules help cause illness?</p>
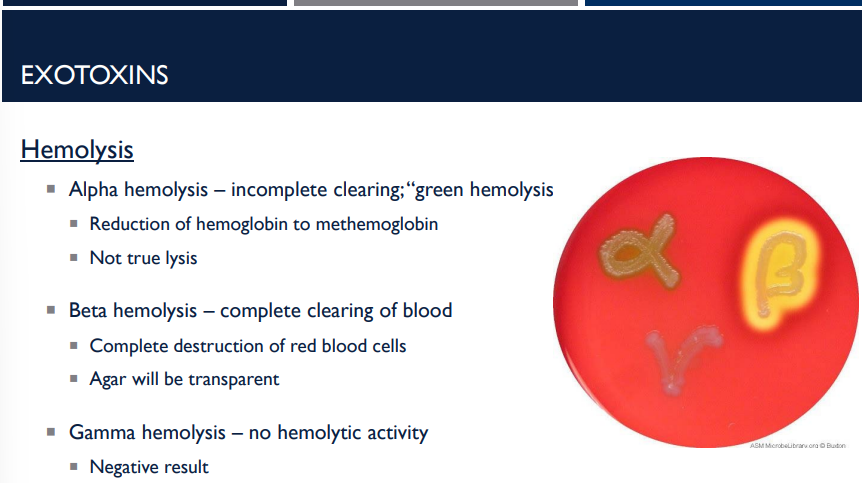
<p>Describe the different types of hemolysis </p>

BIOL 251 Exam 3 - Pathogenicity and Virulence
1/105
There's no tags or description
Looks like no tags are added yet.
Name | Mastery | Learn | Test | Matching | Spaced | Call with Kai |
|---|
No analytics yet
Send a link to your students to track their progress
106 Terms
What is a pathogen?
disease causing organism
What is pathogenicity?
ability of an organism to cause disease by overcoming host defenses
What is virulence?
degree of pathogenicity
Which of the following statements is true?
The primary goal of a pathogen is to kill its host
Evolution selects for the most virulent pathogens
A successful pathogen doesn't kill its host before it is transmitted
A successful pathogen never kills its host
C
The primary goal of a pathogen is to survive and be transmitted. While some pathogens may kill the host, a successful pathogen will not kill the host without first being transmitted to a new host.
What must happen to cause illness?
Gain access to a host (portal of entry)
Adhere to host tissues
Penetrate or evade host defenses
Damage host tissues
What are all the different portals of entry and exit for mucuous membranes?
Mucous membranes
Respiratory tract
Gastrointestinal tract
Genitoturinary tract
Conjunctiva
Parenteral Route
Wound infections
Respiratory tract
Gastrointestinal tract
Genitoturinary tract
Conjunctiva
These are examples of
mucuous membranes, portals of entry and exit
What are all the different portals of entry and exit for the skin?
Skin
Hair follicles
Sweat ducts
What are all the different portals of entry and exit for parenteral routes?
Wound infections
Hair follicles
Sweat ducts
These are examples of
Skin portals of entry and exit
Wound infections are examples of
A parenteral route of portal entry and exit
T/F: lllness or infection may not occur if the organism does not gain access by a preferred portal of entry.
T
T/F: Illness or infection cannot occur if the organism does not gain access by a preferred portal of entry.
F. It MAY NOT occur.

ID 50 stands for
Infectious dose
What is the question that ID50, infectious dose, asks?
How many cells or virions need to enter the body to cause illness in 50% of the population?
The average threshold between sick and not sick for a particular microbe
How many cells or virions need to enter the body to cause illness in 50% of the population? is indicative of what concept?
ID50 - Infectious dose
What is relative virulence in context of the ID50?
Relative virulence – how easily does the organism cause illness under certain conditions?
Lower ID50 = fewer organisms required to cause illness; more easily causes infection
Lower ID50 =
fewer organisms required to cause illness; more easily causes infection

Based on the data below, which genera is most infectious?
Legionella

Based on the data below, which genera causes the most severe illness?
It is impossible to tell. The ID50 indicates how infectious an organism is. It does not indicate how severe the resulting illness will be.
To cause illness, one most adhere to host tissues. What are adhesins?
Adhesins bind to receptors on the host cell.
Attachment is the first step in infection, helping bacteria colonize tissues and resist being washed away by fluids (like mucus or urine).
What helps bacteria colonize tissues and resist being washed away by fluids (like mucus or urine)?
Adherence from adhesins

Glycocalyx
Pili
Fimbriae
Flagella
are all examples of
Adhesins (on bacterial cell)
How do biofilms help cause illness?
Biofilms help the illness adhere due to the glycocalyx – sticky “sugar coat.”
Dental plaque is an example of a
biofilm, helping the illness adhere due to its glycocalyx (sticky sugar coat)
Shower scum is an example of a
biofilm, helping the illness adhere due to its glycocalyx (sticky sugar coat)
Catheters is an example of a
biofilm, helping the illness adhere due to its glycocalyx (sticky sugar coat)
Feeding tubes are an example of a
biofilm, helping the illness adhere due to its glycocalyx (sticky sugar coat)
65% of human bacterial infections are examples of
biofilm, helping the illness adhere due to its glycocalyx (sticky sugar coat)
How do capsules help cause illness?
Capsules prevent recognition by host immune system, helping to evade and penetrate host defenses.
What do
Streptococcus pneumoniae
Klebsiella pneumoniae
Haemophilus influenzae
Bacillus anthrasis
Yersinia pestis
possess to prevent recognition by the host immune system?
capsules
What are the 3 cell wall components?
Streptococcus pyogenes
Neisseria gonorrheae
Mycobacterium tuberculosis

Describe the cell wall component, which helps evade and penetrate host defenses, streptococcus pyogenes.
Streptococcus pyogenes – M-protein for attachment to host cells and evasion of immune system

Describe the cell wall component, which helps evade and penetrate host defenses, neisseria gonorrheae.
Outer membrane protein for attachment to host cells; bacteria replicate inside host cells.

Describe the cell wall component, which helps evade and penetrate host defenses, mycobacterium tuberculosis.
mycolic acid for protection from host immune system
How does the enzyme coagulase help evade and penetrate host defenses?
clot blood (fibrin)
How does the enzyme lipase help evade and penetrate host defenses?
breaks down lipids
How does the enzyme kinase help evade and penetrate host defenses?
digest blood clots
How does the enzyme hyluronidase help evade and penetrate host defenses?
breaks down hyaluronic acid
How does the enzyme collagenase help evade and penetrate host defenses?
breaks down collagen
How does the enzyme IgA protease help evade and penetrate host defenses?
breaks down IgA antibodies
How does the enzyme lecithinase help evade and penetrate host defenses?
break down phospholipids
How does the enzyme DNAse help evade and penetrate host defenses?
breaks down DNA
Alteration of the host cell cytoskeleton helps
invade host cells
Alteration of the host cell cytoskeleton helps invade host cells. Describe the role of actin and invasins.
Actin is a major component of host cytoskeleton. Invasins are bacterial proteins that disrupt the host actin, causing membrane ruffling.
This allows bacteria to enter host cells
Escherichia coli
Salmonella

Alteration of the host cell cytoskeleton helps invade host cells. Describe the role of actin and actin polymerization.
Actin is a major component of host cytoskeleton. Actin polymerization is when the actin is deissamebled and reassembled behind the bacterial cell.
This allows for movement within and between host cells
Listeria monocytogenes
To cause illness, one must damage host tissues. What are the 3 ways to do this?
Steal nutrients
Direct cell damage
Toxins
Stealing nutrients allow damage to host cells. How does this work?
Siderophores. Siderophores are iron-chelating (iron-binding) molecules made and released by bacteria (and some fungi) to help them capture iron from their environment or host. Sequester iron.
Direct cell damage allow damage to host cells. How does this work?
Penetration of host cell membrane
Replication inside host cells
Toxins allow damage to host cells. How do they work? (4 things they do)
Inhibit protein synthesis
Damage eukaryotic membranes
Damage DNA
Provoke an intense immune response
The following can result from
Fever Cardiovascular disturbance Diarrhea Shock Destroy red blood cells Spasms Death
Toxins, which damage host cells by inhibiting protein synthesis, damaging eukaryotic membranes, damaging DNA, and provoking an intense immune response.
What is the LD 50?
Lethal dose for 50% of the population.
Deals with the potency of toxins — How much toxin must enter the body to kill 50% of the population
What is the LD50 measured in?
ng/kg body weight
Lower LD50 =
less toxin required to cause death; more potent toxin

Which of these toxins is the most potent?
Botulinum toxin

What are exotoxins? (toxic proteins)
Toxins produced and excreted from some bacterial cells (Gram + or Gram -)

Exotoxins are toxin proteins that are produced and excreted from some bacterial cells. How do they function in illness?
Proteins (often enzymes)
Destroy parts of host cells
Inhibit metabolic functions
Small doses are harmful (low LD50)
Can act multiple times

T/F: Small doses of LD50 (Low LD50) is not harmful.
F, small doses are harmful (low LD50)

Where are exotoxins carried on?
Carried on plasmids or prophage regions
Horizontal gene transfer
Phage conversion
more info
The genes that make exotoxins are often found on plasmids (small circular DNA pieces) or prophages (viral DNA integrated into the bacterial genome).
Horizontal gene transfer:
These toxin genes can spread between bacteria, allowing new strains to become more virulent (more harmful).Phage conversion:
This happens when a bacteriophage (virus that infects bacteria) inserts its DNA into the bacterial chromosome and gives it new traits — for example, toxin production.
→ Example: Corynebacterium diphtheriae only makes diphtheria toxin when it’s infected by a specific phage.

What are the function of AB exotoxins (2 functions)?
Inhibition of protein synthesis
Corynebacterium diphtheriae
Shigella dysenteriae
Escherchia coli O157:H7
Genotoxins — damage eukaryotic DNA

What are genotoxins?
A type of AB exotoxin that damages eukaryotic DNA like Helicobacter pylori

What does the A & B in AB Toxins stand for?
A – Active component
B – Binding component

AB toxins, a type of exotoxin, enters the cell through what?
receptor-mediated endocytosis

Describe the first step of A-B toxins and how they invade shit
B component binds to host cell receptor
Toxin enters cell by receptor-mediated endocytosis

Describe the second step of A-B toxins and how they invade shit
A and B components separate
B component leaves cell
A component alters host cell function

What are membrane-disrupting toxins?
A type of exotoxin that damage or destroy the plasma membrane of host cells.
→ Result: the cell leaks contents, loses integrity, and dies.

What are leukocidins?
A type of exotoxin, specifically a membrane-disrupting toxin, that kill white blood cells and macrophages

What are hemolysins?
A type of exotoxin, specifically a membrane-disrupting toxin, that kill red blood cells by forming protein channels
How do hemolysins kill red blood cells?
by forming protein channels

What do leukocidins, a type of exotoxin membrane-disrupting toxin, kill?
white cells and macrophages
Streptococcus spp. are also known as
streptolysins
Describe the different types of hemolysis
Alpha hemolysis – incomplete clearing; “green hemolysis”
Reduction of hemoglobin to methemoglobin
Not true lysis
Beta hemolysis – complete clearing of blood
Complete destruction of red blood cells
Agar will be transparent
Gamma hemolysis – no hemolytic activity
Negative result

What are superantigens?
A special type of exotoxin that cause an overreaction of the immune system — basically, they make your immune system go into overdrive and damage the body by provoking an intense immune response.

Superantigens, a special type of exotoxin that cause an overreaction of the immune system by provoking an intense immune response, do so how?
The release of cytokines
Proliferation of T cells

Toxic shock syndrome is caused by what species?
Staphyloccous species
Streptococcus species

The release of cytokines and proliferation of T cells, provoking an intense immune response, is indicative of which exotoxin?
superantigens
What is toxic shock syndrome caused by?
a special exotoxin, superantigen-producing bacteria, mainly:
Staphyloccous species
Streptococcus species

Where are endotoxins produced? When are they release? What do they induce the release of?
As part of the gram negative bacterial cell wall
Released during cell division and cell death
Induce release of cytokines
What is the difference between endotoxins and exotoxins?
Exotoxins are highly toxic proteins secreted by bacteria (mostly Gram-positive), while endotoxins are less toxic lipopolysaccharides that are part of the outer membrane of Gram-negative bacteria and are released upon cell death

T/F: Exotoxins are less toxic lipopolysaccharides that are part of the outer membrane of Gram-negative bacteria and are released upon cell death.
F, this is true of endotoxins, not exotoxins

T/F: Endotoxins are less toxic lipopolysaccharides that are part of the outer membrane of Gram-negative bacteria and are released upon cell death
T

What is the mode of action for endotoxins?
Macrophage eats Gram-negative bacterium → bacterium releases endotoxin → macrophage releases cytokines → too many cytokines → fever, shock, possible death.
Bacterial cells are ingested by macrophages
Macrophages digest bacterial cells
Bacteria release endotoxin
Induces production of cytokines (signaling molecules that stimulate the immune system)
Macrophage eats Gram-negative bacterium → what happens next? (endotoxin mode of action steps)
Macrophage eats Gram-negative bacterium → bacterium releases endotoxin → macrophage releases cytokines → too many cytokines → fever, shock, possible death.
Bacterium releases endotoxin → macrophage releases cytokines → what happens next? (Endotoxin mode of action steps)
Macrophage eats Gram-negative bacterium → bacterium releases endotoxin → macrophage releases cytokines → too many cytokines → fever, shock, possible death.

What induces the following symptoms?
Fever
Chills
Weakness
Aches
Septic shock
Miscarriage
Death
Cytokines. High levels of cytokines are toxic.

T/F: In order to fight bacteria, cytokine is released. This means that high levels of cytokines are one of the best natural responses to fighting bacteria.
F. High levels of cytokines are actually toxic.

T/F: High levels of cytokines are toxic.
T
Which of the following statements regarding bacterial toxins is FALSE?
Endotoxins are produced only by Gram negative bacteria.
Exotoxins are more potent than endotoxins.
Exotoxins are composed of protein.
Endotoxins are composed of lipids.
All exotoxins are A-B exotoxins.
E
Exotoxins are composed of protein. Exotoxins usually act as enzymes, which makes them more potent than endotoxins. While some exotoxins are A-B toxins, there are many other types of exotoxin (superantigens, genotoxins, membrane-disrupting toxins).
Endotoxins are lipids that are found in the outer membrane of Gram negative cells. Endotoxins can not be produced by Gram positive cells.

Regarding the pathogenic properties of viruses, how are host responses evaded?
Intracellular pathogens
Mimic host
Attacking the immune system
Viruses survive by hiding (intracellular), disguising (mimic host), or disabling (attack immune system) the body’s defenses.

What are cytopathic effects?
visible effects of a viral infection

Cytopathic effects are the ______ changes that occur in host cells as a result of viral infection.
visible

When viruses take over host machinery, they stop ______ synthesis in host cells.
macromolecular (protein, DNA, RNA)

Viral infection can cause ______ to rupture, releasing digestive enzymes that destroy the host cell.
Lysosomes

Chromosomal damage caused by viruses can lead to ______ or abnormal cell function.
Mutations (chromosomal damage)

Fusion of neighboring host cells into one large multinucleated cell is called ______ ______ .
Syncytium formation

A syncytium is one large cell with multiple ____.
nuclei

Viral infection can alter host cell surface ______, causing the immune system to attack infected cells.
Antigens (antigenic changes)

Loss of ______ inhibition leads to _____ _____ ____, which can resemble ____.
contact; uncontrolled cell growth; cancer

____ are antiviral proteins produced by infected cells that warn neighboring cells and help them resist infection.
Interferons